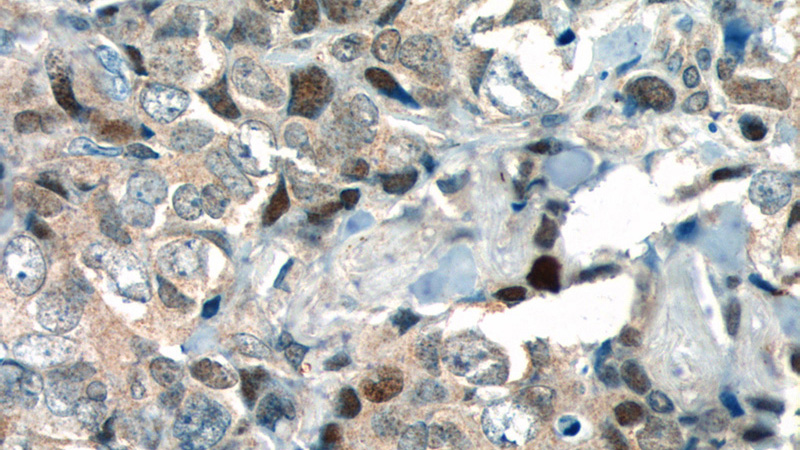
Immunohistochemistry of paraffin-embedded human breast cancer tissue slide using Catalog No:112041(KI67 Antibody) at dilution of 1:400 (under 40x lens). heat mediated antigen retrieved with Sodium Citrate buffer (pH6).

-
Product Name
KI67 antibody
- Documents
-
Description
KI67 Rabbit Polyclonal antibody. Positive IHC detected in human breast cancer tissue, human spleen tissue. Positive IF detected in HepG2 cells.
-
Tested applications
ELISA, IF, IHC
-
Species reactivity
Human; other species not tested.
-
Alternative names
Antigen KI 67 antibody; Ki 67 antibody; KI67 antibody; KIA antibody; MKI67 antibody
-
Isotype
Rabbit IgG
-
Preparation
This antibody was obtained by immunization of Peptide (Accession Number: NM_002417). Purification method: Antigen affinity purified.
-
Clonality
Polyclonal
-
Formulation
PBS with 0.1% sodium azide and 50% glycerol pH 7.3.
-
Storage instructions
Store at -20℃. DO NOT ALIQUOT
-
Applications
Recommended Dilution:
IHC: 1:50-1:500
IF: 1:50-1:500
-
Validations

Immunofluorescent analysis of (10% Formaldehyde) fixed HepG2 cells using Catalog No:112041(KI67 Antibody) at dilution of 1:100 and Alexa Fluor 488-congugated AffiniPure Goat Anti-Rabbit IgG(H+L)

Immunohistochemistry of paraffin-embedded human breast cancer tissue slide using Catalog No:112041(KI67 Antibody) at dilution of 1:400 (under 10x lens). heat mediated antigen retrieved with Sodium Citrate buffer (pH6).
Immunohistochemistry of paraffin-embedded human breast cancer tissue slide using Catalog No:112041(KI67 Antibody) at dilution of 1:400 (under 40x lens). heat mediated antigen retrieved with Sodium Citrate buffer (pH6).
-
Background
MKI67 gene encodes a nuclear protein, antigen KI-67, which was identified by monoclonal antibody Ki-67. Expression of this antigen occurs preferentially during late G1, S, G2 and M phases of the cell cycle, while in cells in G0 phase the antigen cannot be detected (PMID: 8227122). The antigen Ki-67 is a human nuclear protein the expression of which is strictly associated with cell proliferation and which is widely used in routine pathology as a "proliferation marker" to measure the growth fraction of cells in human tumors (PMID: 8227122).
-
References
- Ma X, Wang Q, Liu Y. Inhibition of tumor growth by U0126 is associated with induction of interferon-γ production. International journal of cancer. 136(4):771-83. 2015.
- Fei F, Li X, Xu L. CD147-CD98hc complex contributes to poor prognosis of non-small cell lung cancer patients through promoting cell proliferation via the PI3K/Akt signaling pathway. Annals of surgical oncology. 21(13):4359-68. 2014.
- Zong H, Zhang Y, You Y, Cai T, Wang Y. Decreased Warburg effect induced by ATP citrate lyase suppression inhibits tumor growth in pancreatic cancer. Medical oncology (Northwood, London, England). 32(3):85. 2015.
- Chang H, Dong T, Ma X. Spondin 1 promotes metastatic progression through Fak and Src dependent pathway in human osteosarcoma. Biochemical and biophysical research communications. 464(1):45-50. 2015.
- Zhang Y, Wang Y, Wei Y. MiR-129-3p promotes docetaxel resistance of breast cancer cells via CP110 inhibition. Scientific reports. 5:15424. 2015.
- Tie K, Zhang X, Tan Y. Intrauterine low-functional programming of IGF1 by prenatal nicotine exposure mediates the susceptibility to osteoarthritis in female adult rat offspring. FASEB journal : official publication of the Federation of American Societies for Experimental Biology. 30(2):785-97. 2016.
- He Y, Cao X, Liu X. Quercetin reverses experimental pulmonary arterial hypertension by modulating the TrkA pathway. Experimental cell research. 339(1):122-34. 2015.
- He Q, Ren X, Chen J. miR-16 targets fibroblast growth factor 2 to inhibit NPC cell proliferation and invasion via PI3K/AKT and MAPK signaling pathways. Oncotarget. 7(3):3047-58. 2016.
Related Products / Services
Please note: All products are "FOR RESEARCH USE ONLY AND ARE NOT INTENDED FOR DIAGNOSTIC OR THERAPEUTIC USE"
